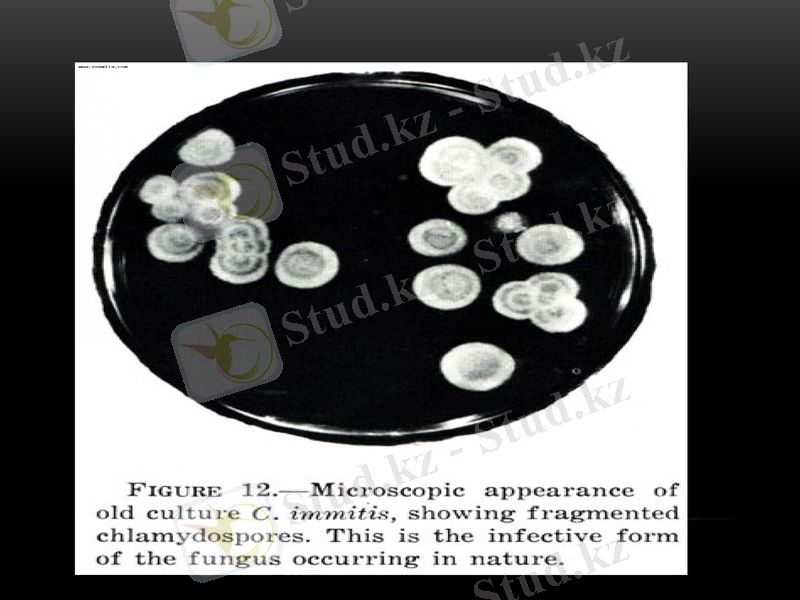
Slide 13

Микоз қоздырғыштары: жіктелуі, сипаттамасы және диагностикасы



ЖМ:104
Орындаган: Суйунбек Н.
Кабылдаган:Байтурсынов К.

Тақырыбы:
Микоз қоздырғыштары.

Жоспар:
Микоз анықтамасы
Микоздың жіктемесі
Микоз түрлеріне сипаттама
Микоздардың диагностикасы

Саңырауқұлақтар тудыратын аурулар микоздар деп аталады. Аурулардың атаулары кейде патологиялық үрдістің орналасуына (теріде-дерматомикоздар, өкпеде-пневмомикоздар т. б) кейде-қоздырғыштардың түрімен(мукоромикоз, аспергиллез, трихофития т. б) байланысты.

Микоз қоздырғыштарының жіктелуі:

Микоздардың сипаттамасы:
Терең микоздар туберкулез таяқшасы мен актиномиоциттер тудыратын созылмалы бактериялық инфекцияларға ұқсас. Алғашқыда әдетте өкпелерді зақымдап, жедел пневмония түрінде өтеді, кейде гематогендік жолмен бүкіл ағзаға таралады. Ауру жұқпалы емес. Антибиотиктер ашылғанға дейінгі кезеңде бұл ауру өліммен аяқталатын. Қоздырғыштары:Coccidioides immitis, Histoplasma capsulatum, Blastomyces dermatitidis.




Оппортунистикалық микоздар-аспергиллездар, кандидоздар, мукороздар және т. б. иммунДЫ тапшылық нәтижесінде п. б. Қоздырғыштардың көбі қалыпты адам микрофлорасына жатады. Клиникалық көрінісі үрдістің орналасуымен анықталады. Аурудың нәтижесі көбінесе ағзаның қалпымен байланысты. Қоздырғыштары:Candida albicans, Aspergillus, Mucor, Penicillium.

Кокцидиоидоздың қоздырғышы(Сoccidioides immitis)
Кокцидиоидоз-жүйелі микоз, көбінесе тыныс жолдарының мүшелі зақымдануымен сипатталады.
Морфологиясы:Диморфты саңырауқұлақтар. Табиғи және бөлмелік температура (20-22С ) жағдайында мицелиялық түрінде дамиды.
Дақылдық қасиеттері:Қарапайым қоректік ортада өседі. Бөлме температурасында Сабуро ортасында ақ, сұр және қоңыр түсті әртүрлі колониялар түзеді.
Антигендік құрылымы:Мицелиялық түрі 3 тәулік бойы сұйық қоректік ортада өскенде HS, F, HL экзоантигендерді түзеді.

Резистенттілігі:Саңырауқұлақтың артроспоралары қоршаған орта факторларының әсеріне төзімді. Антибиотиктер(амфотерицин В, кетоконазол, миконазол) мен кеңінен қолданылатын антисептиктер және дезинфектанттарға сезімтал.
Эпидемиологиясы:Саңырауқұлақтардың экологиялық мекені-эндемиялық аймақтардың топырақтары. Саңырауқұлақ көбінесе құмды және шөлді жерлерде кездеседі. Ауру адам айналасына жұқпалы емес, таралу механизмі-аэрогенді, ауа шаң арқылы .
Патогенезі. Ағзада артроспоралар тіндік пішінде-сферулаға трансформацияланады немесе айналады. Сферулалар домалақ, қалың екі қабатты жасушалық қабырғаға ие.

Алдын алуы:Арнайы сақтандыруы жасалмаған. Зертхана ішілік жұқтыруды алдын алу үшін барлық күдік келтіретін материалдардың бетіне стерилді физиологиялық ерітінділер құйып зерттейді.




Микоздардың диагностикасы
Микоздарға диагноз қою үшін микроскопиялық, серологиялық, биологиялық, және гистологиялық әдістер қолданылады. Патогенезіне баиланысты зерттеу материалдары:ірің, қақырық, зақымдалған шаштар, тырнақ, ликвор, лимфа түйіндері мен ішкі мүшелер, қан, өт, нәжіс, тіннің биопаттары және т. б.

Микроскопиялық әдіс бойынша нативті және боялған жағындылардың микроскопта зерттелуі. Бұл әдіс саңырауқұлаұтардың құрылысын, споралардың орналасуын зарттеуге мүмкіндік береді. Жағынды көбінесе Грам, Циль Нильсон, Романовский Гимзе әдістері арқылы зерттеледі.
Саңырауқұлақтар қоздыратын ауруларға диагноз қою үшін жалпы әдістемелер бойынша саңырауқұлақтық антигендермен серологиялық реакциялар қолданылады.

Биологиялық зерттеулерді зертханалық үлгілерде жүргізеді(тышқан, егеуқұйрық, теңіз шошқасы, орқоян, ит, мысық ) . Микоздардың биологмялық үлгісін қоздырғыштырдың патогендігін, таза дақылды бөліп алу және жаңа микоздарға қарсы препараттарды зерттеу ушін қолданады.
Гистологиялық зерттеу тіндегі саңырауқұлақты, оның мрофологиясын, ағзадағы тудырған потологиялық үрдістің ерекшелігін зерттеуге мүмкіншілік береді.

Назар аударғандарыңызға рахмет!!!
- Іс жүргізу
- Автоматтандыру, Техника
- Алғашқы әскери дайындық
- Астрономия
- Ауыл шаруашылығы
- Банк ісі
- Бизнесті бағалау
- Биология
- Бухгалтерлік іс
- Валеология
- Ветеринария
- География
- Геология, Геофизика, Геодезия
- Дін
- Ет, сүт, шарап өнімдері
- Жалпы тарих
- Жер кадастрі, Жылжымайтын мүлік
- Журналистика
- Информатика
- Кеден ісі
- Маркетинг
- Математика, Геометрия
- Медицина
- Мемлекеттік басқару
- Менеджмент
- Мұнай, Газ
- Мұрағат ісі
- Мәдениеттану
- ОБЖ (Основы безопасности жизнедеятельности)
- Педагогика
- Полиграфия
- Психология
- Салық
- Саясаттану
- Сақтандыру
- Сертификаттау, стандарттау
- Социология, Демография
- Спорт
- Статистика
- Тілтану, Филология
- Тарихи тұлғалар
- Тау-кен ісі
- Транспорт
- Туризм
- Физика
- Философия
- Халықаралық қатынастар
- Химия
- Экология, Қоршаған ортаны қорғау
- Экономика
- Экономикалық география
- Электротехника
- Қазақстан тарихы
- Қаржы
- Құрылыс
- Құқық, Криминалистика
- Әдебиет
- Өнер, музыка
- Өнеркәсіп, Өндіріс
Қазақ тілінде жазылған рефераттар, курстық жұмыстар, дипломдық жұмыстар бойынша біздің қор #1 болып табылады.



Ақпарат
Қосымша
Email: info@stud.kz